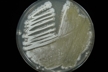

Accessioned in 1983.
=ATCC 25466 =BCRC 11173 =CBS 630.70 =CBS 699.69 =CCM 4150 =DSM 2013 =DSM 40355 =IFO 13054 =ISP 5355 =JCM 4488 =KCTC 1868 =KCTC 9088 =KCTC 9089 =NBIMCC 1526 =NBRC 13054 =NCIMB 9413 =NRRL 2936 =RIA 1246 =VKM Ac-727.
Type strain [685].
Medium: 58; Temperature: 28°C; Rehydration fluid: 656.
open link in new window
 Instructions for an order
Instructions for an order